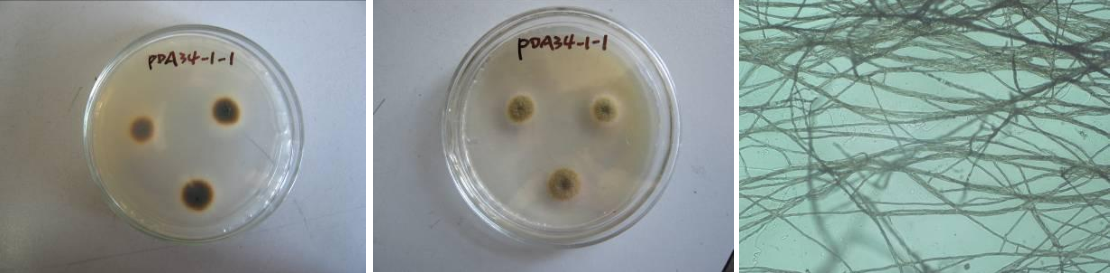

Loading...
| StrainNO | F94 |
| Classification | Phoma |
| 16s rDNA sequence | TGAGTTGTAGGCTTTGCCTGCTATCTCTTACCCATGTCTTTTGAGTACCTTCGTTTCCTCGGCGGGTCCGCCCGCCGATCGGAC AACCATAAACCATTTGCAGTTGCAATCAGCGTCTGAAAAAACTTTAATAGTTACAACTTTCAACAACGGATCTCTTGGTTCTGG CATCGATGAAGAACGCAGCGAAATGCGATAAGTAGTGTGAATTGCAGAATTCAGTGAATCATCGAATCTTTGAACGCACATTGC GCCCCTTGGTATTCCATGGGGCATGCCTGTTCGAGCGTCATTTGTACCTTCAAGCTCTGCTTGGTGTTGGGTGTTTGTCTCGCC TCTGCGCGTAGACTCGCCTCAAAACAATTGGCAGCCGGCGTATTGATTTCGGAGCGCAGTACATCTCGCGCTTTGCACTCATAA CGACGACGTCCAAAAGTACATTTTTACACTCTTGACCTCGGATCAGGTAGGGATACCCGCTGAACTTAAGCATATCAATAAGCG GAGGAA |
| Strain Morphology Photos | |
| Morphological Description | primary hyphae:white;moss:short hairy;spore pile:bamboo leaf green;back: bamboo leaf green to gray black |